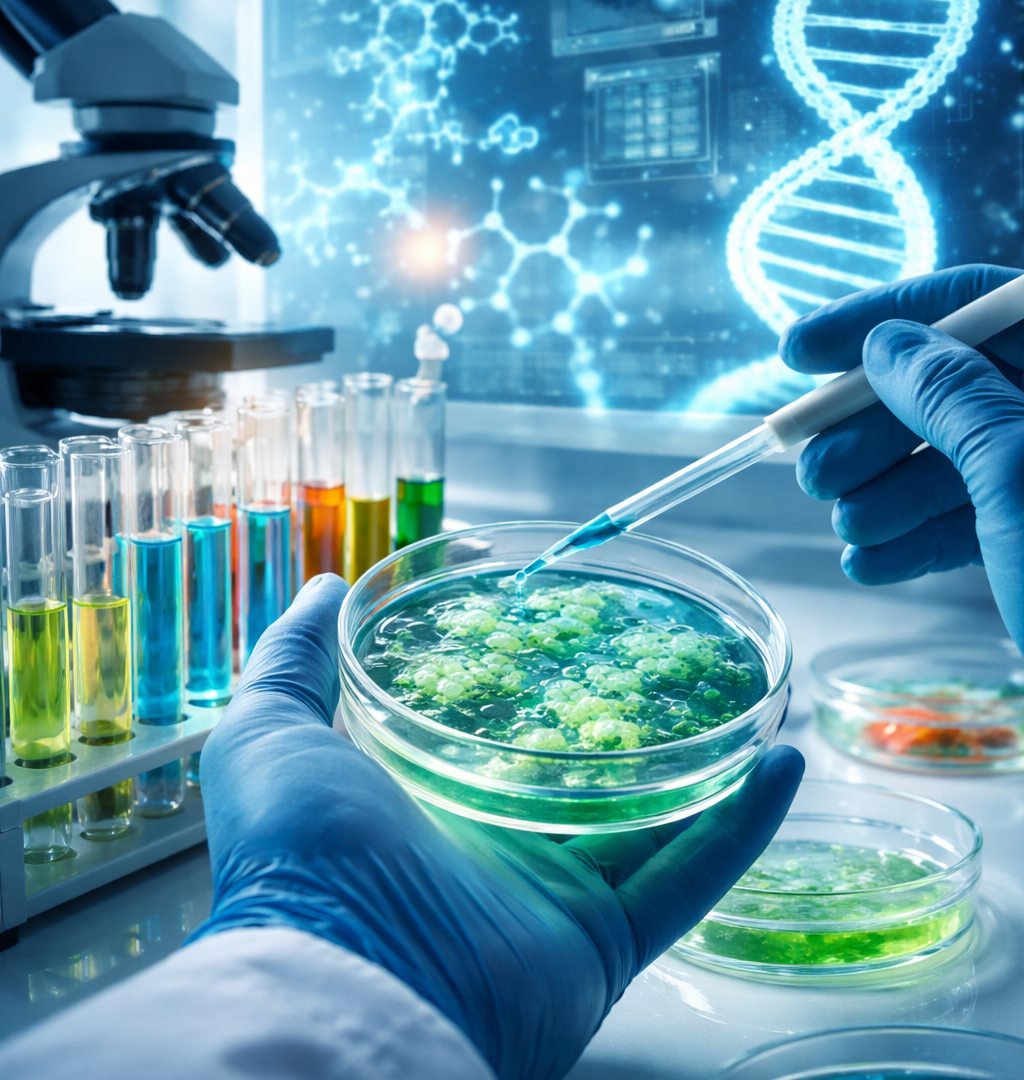
ChatGPT Image 30 janv. 2026, 15_07_50

Assurance biotechnologie difficile à assurer : solutions immédiates
Dès qu’une entreprise évolue dans la biotechnologie, la question de l’assurance devient rapidement centrale, parfois même avant les premières phases de recherche active. Une assurance biotechnologie difficile à assurer n’est pas un simple contrat administratif, mais un véritable outil de sécurisation du projet scientifique, financier et humain. Entre les risques liés à la manipulation du vivant, les investissements lourds en recherche et développement, la dépendance aux autorisations réglementaires et l’incertitude des résultats, les assureurs traditionnels se montrent souvent frileux. Pourtant, sans couverture adaptée, une biotechnologie peut voir ses partenariats bloqués, ses financements suspendus ou ses essais retardés. Dans cet article, nous allons explorer pourquoi la biotechnologie est souvent considérée comme difficile à assurer, les raisons des refus, les solutions concrètes existantes, et surtout comment un accompagnement spécialisé permet de transformer un refus en opportunité assurantielle durable.
Pourquoi une biotechnologie peut-elle être difficile à assurer ?
Une entreprise de biotechnologie cumule des caractéristiques que les assureurs analysent avec une extrême prudence. Contrairement à un commerce classique, elle travaille souvent sur des protocoles expérimentaux dont l’issue est incertaine. Un laboratoire qui développe une thérapie innovante ou un procédé de modification cellulaire engage sa responsabilité bien avant toute mise sur le marché. Le risque n’est pas seulement matériel, il est aussi scientifique, réglementaire et réputationnel.
Prenons l’exemple d’une startup qui manipule des micro-organismes génétiquement modifiés. Même avec des procédures strictes, un incident de confinement peut entraîner des conséquences majeures. Les assureurs évaluent alors la maturité des process, l’expérience de l’équipe dirigeante et la capacité à documenter chaque étape. Une erreur fréquente consiste à sous-estimer l’importance de la traçabilité et à présenter un dossier trop technique, mais peu orienté sur la gestion du risque.
Un autre point critique est la phase de développement. Une biotechnologie en préclinique n’a pas les mêmes besoins ni le même profil de risque qu’une société en phase d’essais cliniques avancés. Beaucoup d’entreprises cherchent une assurance globale sans adapter leur demande à leur stade réel d’activité, ce qui conduit à des refus automatiques. Bien choisir son assurance biotechnologie difficile à assurer implique donc de comprendre son propre niveau d’exposition et d’anticiper les attentes des assureurs dès la constitution du dossier.
Pourquoi les assureurs refusent-ils ?
Les refus d’assurance dans la biotechnologie ne sont pas arbitraires. Ils reposent sur des critères précis qui, cumulés, font basculer un dossier dans la catégorie des risques aggravés. Le premier élément est l’incertitude scientifique. Selon plusieurs études sectorielles, plus de 70 % des projets biotech n’atteignent jamais la phase de commercialisation. Pour un assureur, cette statistique pèse lourdement dans l’évaluation du risque financier.
Le second facteur concerne la responsabilité civile professionnelle. Une biotechnologie peut être tenue responsable d’effets indésirables à long terme, parfois plusieurs années après une expérimentation. Les assureurs craignent les sinistres tardifs, difficiles à chiffrer et potentiellement très coûteux. C’est particulièrement vrai pour les thérapies innovantes ou les dispositifs issus de la biologie synthétique.
À cela s’ajoutent les contraintes réglementaires. Une non-conformité, même mineure, peut entraîner une suspension d’activité ou des sanctions administratives. Les assureurs examinent donc les audits, les autorisations et la veille réglementaire mise en place. Un dossier incomplet ou mal structuré est souvent interprété comme un manque de maîtrise interne.
Enfin, le manque d’historique joue contre les jeunes structures. Sans antériorité de sinistres ou de contrats précédents, l’assureur n’a aucun point de comparaison. C’est pourquoi une assurance biotechnologie difficile à assurer nécessite une présentation pédagogique du projet, traduisant les enjeux scientifiques en langage assurantiel.
Peut-on assurer une biotechnologie difficile à assurer ?
La réponse est oui, à condition d’adopter la bonne stratégie. Assurer une biotechnologie à risque ne consiste pas à forcer l’acceptation d’un contrat standard, mais à construire une solution sur mesure. C’est précisément là qu’intervient le rôle d’un courtier spécialisé. Contrairement à un distributeur généraliste, il sait identifier les assureurs ouverts à des risques complexes et adapter le discours à leurs exigences.
Un courtier va d’abord analyser les points de blocage potentiels. Par exemple, un devis peut sembler attractif en apparence, mais cacher des exclusions majeures sur les essais cliniques ou la responsabilité produit. Sans accompagnement, beaucoup d’entrepreneurs découvrent ces limites trop tard, parfois au moment d’un sinistre.
L’interprétation d’un devis est donc cruciale. Il faut regarder les plafonds de garantie, les franchises, mais aussi les extensions spécifiques. Une biotechnologie travaillant sur des échantillons humains devra vérifier la couverture des atteintes immatérielles et des frais de défense. Les tarifs très bas sont souvent synonymes de garanties minimalistes, inadaptées à la réalité du terrain.
Passer par un cabinet spécialisé permet aussi de négocier. Les assureurs acceptent plus volontiers un risque lorsqu’il est présenté de manière structurée, avec des mesures de prévention claires et un interlocuteur qui comprend leurs contraintes.
Quelles solutions concrètes pour assurer une biotechnologie à risque ?
Il existe plusieurs formules d’assurance adaptées aux biotechnologies, chacune répondant à un besoin spécifique. La responsabilité civile professionnelle constitue la base, mais elle doit être enrichie par des garanties ciblées. Pour un laboratoire de recherche, la couverture des dommages environnementaux peut être déterminante, notamment en cas de contamination accidentelle.
Certaines entreprises optent pour des contrats modulaires, permettant d’ajuster les garanties au fur et à mesure de l’évolution du projet. Cette approche progressive est souvent plus acceptable pour les assureurs et plus économique pour l’entreprise. À l’inverse, une couverture trop large dès le départ peut alourdir inutilement les coûts.
Il faut également considérer les assurances spécifiques aux essais cliniques, souvent distinctes des contrats classiques. Leur avantage réside dans une prise en charge adaptée aux risques humains, mais leur coût et leurs conditions d’accès nécessitent une analyse fine.
La meilleure solution dépend donc de l’activité réelle, du stade de développement et des partenaires impliqués. Une biotechnologie orientée recherche fondamentale n’aura pas les mêmes priorités qu’une société proche de la mise sur le marché. L’objectif est d’obtenir une assurance biotechnologie difficile à assurer qui protège sans freiner l’innovation.
Pourquoi faire appel à un courtier spécialisé ?
Faire appel à un courtier spécialisé, c’est avant tout gagner du temps et de la crédibilité. Les options disponibles dans un contrat biotech sont nombreuses et leur impact sur le prix est significatif. Une extension mal choisie peut doubler la prime sans réelle utilité, tandis qu’une garantie absente peut mettre en péril l’entreprise.
Le courtier joue un rôle de filtre et de traducteur. Il explique aux assureurs les choix technologiques et aux dirigeants les implications contractuelles. Par exemple, certaines options liées à la responsabilité des dirigeants sont souvent négligées, alors qu’elles protègent le patrimoine personnel en cas de litige.
En privilégiant certaines garanties plutôt que d’autres, il est possible d’optimiser le coût global tout en renforçant la protection. Un courtier connaît les pratiques du marché et sait quelles concessions sont négociables. Dans un secteur aussi technique que la biotechnologie, cette expertise fait souvent la différence entre un refus et une acceptation.
Notre accompagnement pour les biotechnologies difficiles à assurer ?
L’accompagnement que nous proposons repose sur une compréhension globale des obligations légales et des réalités du terrain. Une assurance biotechnologie difficile à assurer doit répondre aux exigences minimales en matière de responsabilité civile, mais aussi aux attentes des investisseurs, des partenaires industriels et des autorités.
Nous commençons par un audit complet de votre activité afin d’identifier les risques réels, et non supposés. Cette étape permet de définir la couverture minimale requise et les extensions pertinentes. Nous veillons également à la conformité réglementaire, souvent déterminante dans l’acceptation d’un dossier.
Notre rôle ne s’arrête pas à la signature du contrat. Nous assurons un suivi dans le temps, en adaptant les garanties à l’évolution de votre projet. Cette approche dynamique sécurise votre développement et renforce la confiance de vos partenaires. Dans un secteur où chaque étape compte, disposer d’une assurance adaptée devient un véritable levier de croissance.
Lien utile :
Code des Assurances
